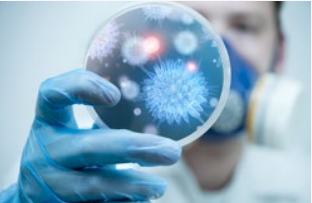
生物氣溶膠采樣器應(yīng)用

AGENT BRAND
品牌專題 1、基于濕式氣旋技術(shù),結(jié)合高流速采樣。
1、基于濕式氣旋技術(shù),結(jié)合高流速采樣。
2、收集生物顆粒包括毒素、病毒、細(xì)菌、霉菌、花粉和孢子,并將其濃縮在液體中。
3、樣品以液體形式輸出可與任何類型的分析兼容,只需幾個(gè)小時(shí)即可獲得可靠的結(jié)果。
 與所有分析方法兼容!強(qiáng)的驚人!
與所有分析方法兼容!強(qiáng)的驚人!
Coriolis ? 是一款創(chuàng)新的生物空氣采樣器,主要用于生物污染評(píng)估,主要用于環(huán)境和污染研究、制藥、食品和獸醫(yī)行業(yè)、生物醫(yī)學(xué)和健康環(huán)境的空氣品質(zhì)控制和監(jiān)測。
基于濕式旋風(fēng)技術(shù),結(jié)合高空氣流量,Coriolis ? 提供了10分鐘內(nèi)最有效的顆粒物收集。樣本液體輸出與任何類型的分析兼容,只需幾小時(shí)即可獲得可靠的結(jié)果。
| 產(chǎn)品名稱 | 貨號(hào) | 產(chǎn)品手冊 |
微生物空氣采樣器 Coriolis Microbial Air Sampler | P001080-CORM0-A.0 | 下載 |
 |  |  | |
| 污染與環(huán)境 | 食品/制藥/獸醫(yī)/工業(yè) | 生物醫(yī)學(xué)與健康 | 研究與開發(fā) |
1、固相細(xì)胞計(jì)數(shù):1 ~ 3h可得結(jié)果,適用于所有的植物系
2、ATP生物熒光:適用于所有植物系
3、 熒光顯微鏡:快速觀察結(jié)果
4、PCR:用于病原體檢測
5、免疫分析:變應(yīng)原檢測
 | 1 - 預(yù)裝有特定液體樣本的無菌錐體 2 - 空氣被吸入并被抽入錐體形成漩渦 3 - 顆粒物被離心到錐體壁上并與空氣分離 4 - 液體樣本中的污染物已準(zhǔn)備好進(jìn)行分析 |
尺寸:22 x 33 x 36 cm
重量:2,8 kg (含電池) 4,3 kg with option
空氣流量:100 to 300 L/min
采樣時(shí)間:1-10 min / up to 6 h
液體輸出體積:15mL
收集顆粒大小:> 0.5 μm
收集效率:D50 <0,5μm
電池續(xù)航:1 hour
自給自足:1小時(shí)(采樣時(shí)間)
消毒:過氧化氫
| 全系列專用耗材 | |||
| 無菌液體收集管 | 無菌和非無菌錐體及蓋子(一次性使用) | 長時(shí)間監(jiān)測配件 | |
 |  |  |  |

微信掃碼在線客服